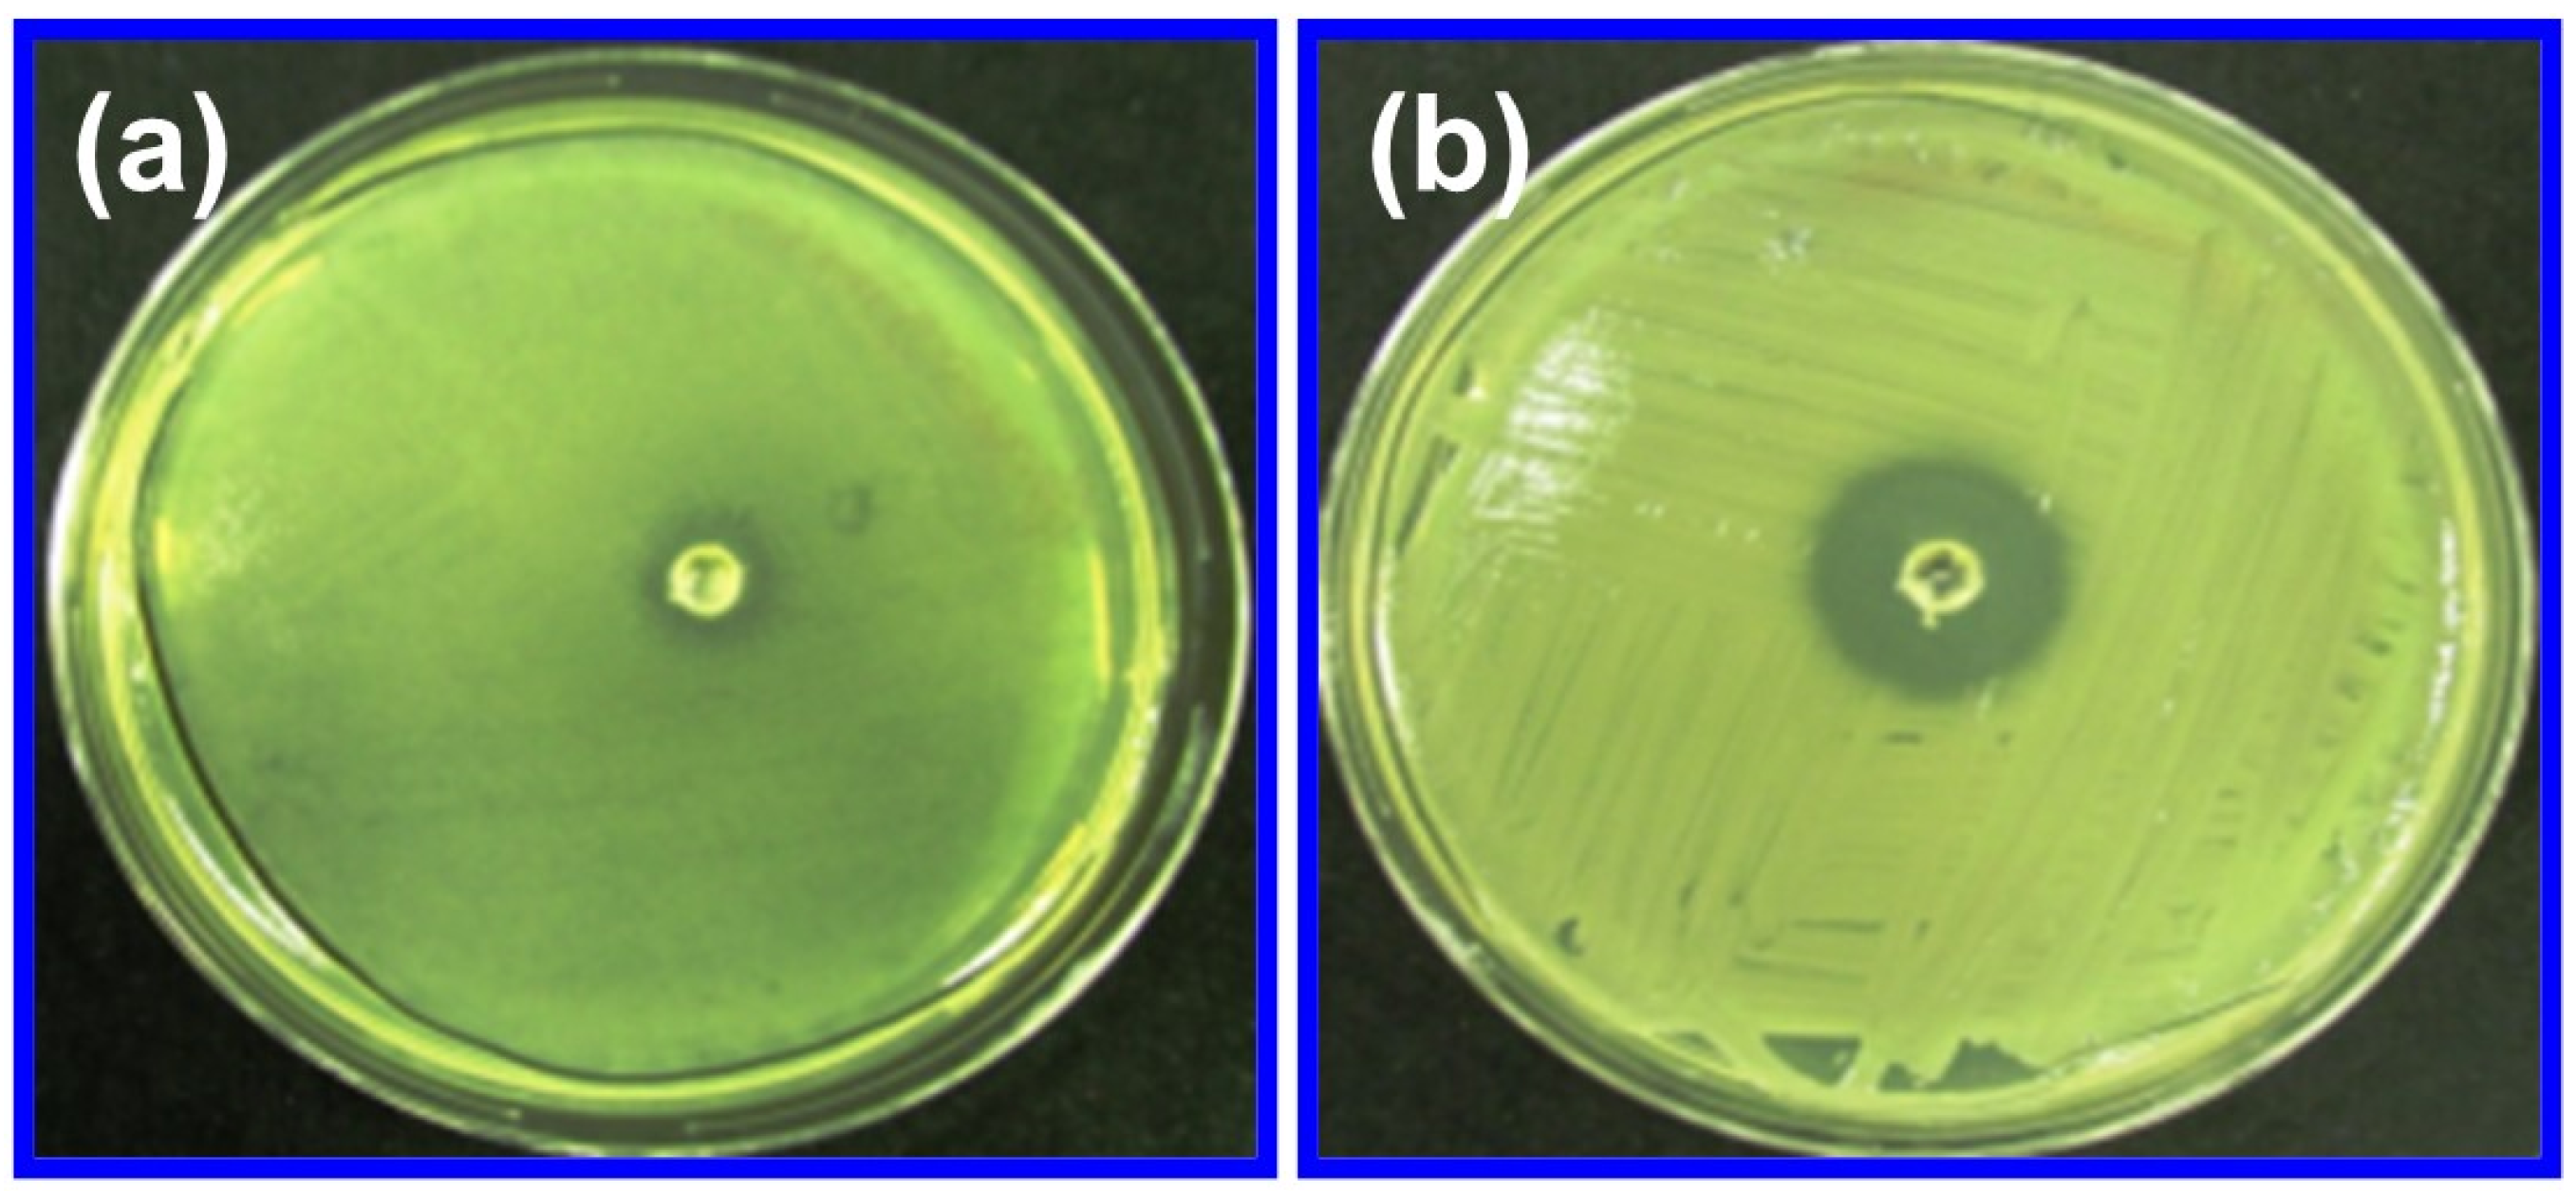
Molecules 29 01464 g007

A Study on the Antibacterial, Antispasmodic, Antipyretic, and Anti-Inflammatory Activity of ZnO Nanoparticles Using Leaf Extract from Jasminum sambac (L. Aiton)
Abstract
1. Introduction
2. Results and Discussion
2.1. FTIR Analysis
2.2. XRD Analysis
2.3. Results of UV-Visible Spectroscopy Analysis
2.4. SEM Analysis
2.5. TEM Analysis
2.6. Thermal Analysis
2.7. Results of Biological Studies of ZnO NPs
2.7.1. Antibacterial Activity
2.7.2. Antispasmodic Activity
2.7.3. Antipyretic Activity
2.7.4. Anti-Inflammatory Activity
2.7.5. Evaluation of Cytotoxicity
3. Materials and Methods
3.1. Materials
3.2. Preparation of JS Leaves Extract
3.3. Green Synthesis of ZnO Nanoparticles
3.4. Characterization
3.4.1. Fourier Transform Infrared Spectroscopy (FTIR)
3.4.2. X-ray Diffraction (XRD)
3.4.3. UV-Visible Spectroscopy
3.4.4. Scanning Electron Microscopy (SEM)
3.4.5. Transmission Electron Microscopy (TEM)
3.4.6. Thermal Analysis
3.4.7. Biological Studies of ZnO NPs
3.4.8. MTT Assay
3.4.9. Statistical Analysis
4. Conclusions
Supplementary Materials
Author Contributions
Funding
Institutional Review Board Statement
Informed Consent Statement
Data Availability Statement
Acknowledgments
Conflicts of Interest
References
- Singh, M.; Singh, S.; Prasad, S.; Gambhir, I.S. Nanotechnology in Medicine and Antibacterial Effect of Silver Nanoparticles. Dig. J. Nanomater. Biostruct. 2008, 3, 115–122. [Google Scholar]
- Whitesides, G.M. Nanoscience, Nanotechnology, and Chemistry. Small 2005, 1, 172–179. [Google Scholar] [CrossRef]
- Pelaz, B.; Jaber, S.; de Aberasturi, D.J.; Wulf, V.; Aida, T.; de la Fuente, J.M.; Feldmann, J.; Gaub, H.E.; Josephson, L.; Kagan, C.R.; et al. The State of Nanoparticle-based Nanoscience and Biotechnology: Progress, Promises, and Challenges. ACS Nano 2012, 6, 8468–8483. [Google Scholar] [CrossRef] [PubMed]
- Chen, J.; Miao, Y.; He, N.; Wu, X.; Li, S. Nanotechnology and Biosensors. Biotechnol. Adv. 2004, 22, 505–518. [Google Scholar]
- Zhang, X.; Guo, Q.; Cui, D. Recent Advances in Nanotechnology Applied to Biosensors. Sensors 2009, 9, 1033–1053. [Google Scholar] [CrossRef] [PubMed]
- Singh, A.; Dutta, P.K. Green Synthesis, Characterization and Biological Evaluation of Chitin Glucan Based Zinc Oxide Nanoparticles and its Curcumin Conjugation. Int. J. Biol. Macromol. 2020, 156, 514–521. [Google Scholar] [CrossRef] [PubMed]
- Sirelkhatim, A.; Mahmud, S.; Seeni, A.; Kaus, N.H.M.; Ann, L.C.; Bakhori, S.K.M.; Hasan, H.; Mohamad, D. Review on Zinc Oxide Nanoparticles: Antibacterial Activity and Toxicity Mechanism. Nano-Micro Lett. 2015, 7, 219–242. [Google Scholar] [CrossRef]
- Ansari, M.A.; Govindasamy, R.; Begum, M.Y.; Ghazwani, M.; Alqahtani, A.; Alomary, M.N.; Jamous, Y.F.; Alyahya, S.A.; Asiri, S.; Khan, F.A.; et al. Bioinspired Ferromagnetic CoFe2O4 nanoparticles: Potential Pharmaceutical and Medical Applications. Nanotechnol. Rev. 2023, 12, 20230575. [Google Scholar] [CrossRef]
- Tamirat, Y. The Role of Nanotechnology in Semiconductor Industry: Review. J. Mater. Sci. Nanotech. 2017, 5, 202. [Google Scholar]
- Sobolev, K.; Gutiérrez, M.F. How Nanotechnology can Change the Concrete World. Am. Ceram. Soc. Bull. 2005, 84, 16–20. [Google Scholar]
- Zhu, W.; Bartos, P.J.M.; Porro, A. Application of Nanotechnology in Construction. Mater. Struct. 2004, 37, 649–658. [Google Scholar] [CrossRef]
- Havancsak, K. Nanotechnology at Present and its Promise for the Future. Mater. Sci. Forum 2003, 414–415, 85–94. [Google Scholar] [CrossRef]
- Nagajyothi, P.C.; Cha, S.J.; Yang, I.J.; Sreekanth, T.V.M.; Kim, K.J.; Shin, H.M. Antioxidant and Anti-inflammatory Activities of Zinc Oxide Nanoparticles Synthesized using Polygala tenuifolia Root Extract. J. Photochem. Photobiol. B Biol. 2015, 146, 10–17. [Google Scholar] [CrossRef] [PubMed]
- Cai, X.; Luo, Y.; Zhang, W.; Du, D.; Lin, Y. pH-sensitive ZnO Quantum Dots–Doxorubicin Nanoparticles for Lung Cancer Targeted Drug Delivery. ACS Appl. Mater. Interfaces 2016, 8, 22442–22450. [Google Scholar] [CrossRef] [PubMed]
- Yu, H.; Park, J.-Y.; Kwon, C.W.; Hong, S.-C.; Park, K.-M.; Chang, P.-S. An Overview of Nanotechnology in Food Science: Preparative Methods, Practical Applications, and Safety. J. Chem. 2018, 2018, 5427978. [Google Scholar] [CrossRef]
- Rai-Kalal, P.; Jajoo, A. Priming with Zinc Oxide Nanoparticles Improve Germination and Photosynthetic Performance in Wheat. Plant Physiol. Biochem. 2021, 160, 341–351. [Google Scholar] [CrossRef]
- Agnieszka, K.-R.; Jesionowski, T. Zinc Oxide-from Synthesis to Application: A Review. Materials 2014, 7, 2833–2881. [Google Scholar]
- Hymavathi, A.; Nizamuddin, S.; Bantikatla, H. Design, Green Synthesis and Characterization of Zinc Oxide Nanoparticles from Ocimum tenuiflorum Var. Ram Tulsi. Mater. Today Proc. 2022, 54, 557–559. [Google Scholar] [CrossRef]
- Nadeem, M.; Tungmunnithum, D.; Hano, C.; Abbasi, B.H.; Hashmi, S.S.; Ahmad, W.; Zahir, A. The Current Trends in the Green Syntheses of Titanium Oxide Nanoparticles and Their Applications. Green Chem. Lett. Rev. 2018, 11, 492–502. [Google Scholar] [CrossRef]
- Gul, R.; Jan, H.; Lalay, G.; Andleeb, A.; Usman, H.; Zainab, R.; Qamar, Z.; Hano, C.; Abbasi, B.H. Medicinal Plants and Biogenic Metal Oxide Nanoparticles: A Paradigm Shift to Treat Alzheimer’s Disease. Coatings 2021, 11, 717. [Google Scholar] [CrossRef]
- Jadoun, S.; Arif, R.; Jangid, N.K.; Meena, R.K. Green Synthesis of Nanoparticles Using Plant Extracts: A Review. Environ. Chem. Lett. 2021, 19, 355–374. [Google Scholar] [CrossRef]
- Sumaira, T.; Khan, B.H.; Abbasi, M.S.; Afridi, F.; Tanveer, I.; Ullah, L.; Bashir, S.; Hano, C. Melatonin-Enhanced Biosynthesis of Antimicrobial AgNPs by Improving the Phytochemical Reducing Potential of a Callus Culture of Ocimum basilicum L. var. thyrsiflora. RSC Adv. 2017, 7, 38699–38713. [Google Scholar] [CrossRef]
- Jan, H.; Shah, M.; Usman, H.; Khan, M.A.; Zia, M.; Hano, C.; Abbasi, B.H. Biogenic Synthesis and Characterization of Antimicrobial and Antiparasitic Zinc Oxide (ZnO) Nanoparticles Using Aqueous Extracts of the Himalayan Columbine (Aquilegia pubiflora). Front. Mater. 2020, 7, 249. [Google Scholar] [CrossRef]
- Shah, M.; Nawaz, S.; Jan, H.; Uddin, N.; Ali, A.; Anjum, S.; Giglioli-Guivarc’h, N.; Hano, C.; Abbasi, B.H. Synthesis of Bio-mediated Silver Nanoparticles from Silybum Marianum and Their Biological and Clinical Activities. Mater. Sci. Eng. C 2020, 112, 110889. [Google Scholar] [CrossRef] [PubMed]
- Razavi, M.; Salahinejad, E.; Fahmy, M.; Yazdimamaghani, M.; Vashaee, D.; Tayebi, L. Green Chemical and Biological Synthesis of Nanoparticles and Their Biomedical Applications. In Green Processes for Nanotechnology: From Inorganic to Bio Inspired Nanomaterials; Springer: Cham, Switzerland, 2015; pp. 207–235. [Google Scholar]
- Aravind, M.; Ahmad, A.; Ahmad, I.; Amalanathan, M.; Naseem, K.; Mary, S.M.M.; Parvathiraja, C.; Hussain, S.; Algarni, T.S.; Pervaiz, M.; et al. Critical Green Routing Synthesis of Silver NPs Using Jasmine Flower Extract for Biological Activities and Photocatalytical Degradation of Methylene Blue. J. Environ. Chem. Eng. 2021, 9, 104877. [Google Scholar] [CrossRef]
- Ali, S.G.; Ansari, M.A.; Khan, H.M.; Jalal, M.; Mahdi, A.A.; Cameotra, S.S. Antibacterial and Antibiofilm Potential of Green Synthesized Silver Nanoparticles against Imipenem Resistant Clinical Isolates of P. aeruginosa. BioNanoScience 2018, 8, 544–553. [Google Scholar] [CrossRef]
- Guo, B.-L.; Han, P.; Guo, L.-C.; Cao, Y.-Q.; Li, A.-D.; Kong, J.-Z.; Zhai, H.; Wu, D. The Antibacterial Activity of Ta-doped ZnO Nanoparticles. Nanoscale Res. Lett. 2015, 10, 1047. [Google Scholar] [CrossRef]
- Hajipour, M.J.; Fromm, K.M.; Ashkarran, A.A.; De Aberasturi, D.J.; De Larramendi, I.R.; Lu, J.; Serpooshan, V.; Parak, W.J.; Mahmoudi, M. Antibacterial properties of nanoparticles. Trends Biotechnol. 2012, 30, 499–511. [Google Scholar] [CrossRef] [PubMed]
- Ansari, M.A.; Murali, M.; Prasad, D.; Alzohairy, M.A.; Almatroudi, A.; Alomary, M.N.; Udayashankar, A.C.; Singh, S.B.; Asiri, S.M.M.; Ashwini, B.S.; et al. Cinnamomum verum Bark Extract Mediated Green Synthesis of ZnO Nanoparticles and Their Antibacterial Potentiality. Biomolecules 2020, 10, 336. [Google Scholar] [CrossRef] [PubMed]
- Ali, J.; Mazumder, J.A.; Perwez, M.; Sardar, M. Antimicrobial Effect of ZnO Nanoparticles Synthesized by Different Methods Against Food Borne Pathogens and Phytopathogens. Mater. Today Proc. 2021, 36, 609–615. [Google Scholar] [CrossRef]
- Fardood, S.T.; Ramazani, A.; Moradi, D.; Asiabi, P.A. Green Synthesis of Zinc Oxide Nanoparticles Using Arabic Gum and Photocatalytic Degradation of Direct Blue 129 Dye Under Visible Light. J. Mater. Sci. Mater. Electron. 2017, 28, 13596–13601. [Google Scholar] [CrossRef]
- Vinayagam, R.; Selvaraj, R.; Pugazhendhi, A.; Varadavenkatesan, T. Synthesis, Characterization and Photocatalytic Dye Degradation Capability of Calliandra Haematocephala-Mediated Zinc Oxide Nanoflowers. J. Photochem. Photobiol. B Biol. 2020, 203, 111760. [Google Scholar] [CrossRef]
- Srinet, G.; Sharma, S.; Kumar, M.; Anshul, A. Structural and Optical Properties of Mg Modified ZnO Nanoparticles: An X-ray Peak Broadening Analysis. Phys. E Low-Dimens. Syst. Nanostruct. 2021, 125, 114381. [Google Scholar] [CrossRef]
- Junaid, M.; Hussain, S.G.; Abbas, N. Band Gap Analysis of Zinc Oxide for Potential Bio Glucose Sensor. Results Chem. 2023, 5, 100961. [Google Scholar] [CrossRef]
- Muchuweni, E.; Sathiaraj, T.S.; Nyakotyo, H. Synthesis and Characterization of Zinc Oxide Thin Films for Optoelectronic Applications. Heliyon 2017, 3, e00285. [Google Scholar] [CrossRef] [PubMed]
- Peña-Garcia, R.; Guerra, Y.; Milani, R.; Oliveira, D.M.; Rodrigues, A.R.; Padrón-Hernández, E. The Role of Y on the Structural, Magnetic and Optical Properties of Fe-Doped ZnO Nanoparticles Synthesized by Sol Gel Method. J. Magn. Magn. Mater. 2020, 498, 166085. [Google Scholar] [CrossRef]
- Vivekanandhan, S.; Schreiber, M.; Mason, C.; Mohanty, A.K.; Misra, M. Maple Leaf (Acer sp.) Extract Mediated Green Process for the Functionalization of ZnO Powders with Silver Nanoparticles. Colloids Surf. B. 2014, 113, 169–175. [Google Scholar] [CrossRef] [PubMed]
- Fang, X.; Miao, S.; Zhang, Y.; Chen, Z.; Lai, Y.; Yang, Y.; Cheng, S.; Fan, S.; Yang, J.; Zhang, Y.; et al. Green Synthesis and Characterization of an Orally Bioactive Artemisinin-Zinc Nanoparticle with Enhanced Bactericidal Activity. Colloids Surf. B. 2024, 234, 113660. [Google Scholar] [CrossRef]
- Wu, J.; Sun, Q.; Huang, H.; Duan, Y.; Xiao, G.; Le, T. Enhanced Physico-Mechanical, Barrier and Antifungal Properties of Soy Protein Isolate Film by Incorporating Both Plant-Sourced Cinnamaldehyde and Facile Synthesized Zinc Oxide Nanosheets. Colloids Surf. B. 2019, 180, 31–38. [Google Scholar] [CrossRef]
- Puišo, J.; Jonkuvienė, D.; Mačionienė, I.; Šalomskienė, J.; Jasutienė, I.; Kondrotas, R. Biosynthesis of Silver Nanoparticles Using Lingonberry and Cranberry Juices and Their Antimicrobial Activity. Colloids Surf. B. 2014, 121, 214–221. [Google Scholar] [CrossRef] [PubMed]
- Jayachandran, A.; Aswathy, T.R.; Nair, A.S. Green Synthesis and Characterization of Zinc Oxide Nanoparticles Using Cayratia pedata Leaf Extract. Biochem. Biophys. Rep. 2021, 26, 100995. [Google Scholar] [CrossRef]
- Bai, X.; Wang, L.; Zong, R.; Lv, Y.; Sun, Y.; Zhu, Y. Performance Enhancement of ZnO Photocatalyst via Synergic Effect of Surface Oxygen Defect and Graphene Hybridization. Langmuir 2013, 29, 3097–3105. [Google Scholar] [CrossRef]
- Rajendran, N.K.; George, B.P.; Houreld, N.N.; Abrahamse, H. Synthesis of Zinc Oxide Nanoparticles Using Rubus Fairholmianus Root Extract and Their Activity against Pathogenic Bacteria. Molecules 2021, 26, 3029. [Google Scholar] [CrossRef]
- Albeladi, S.S.R.; Malik, M.A.; Al-thabaiti, S.A. Facile Biofabrication of Silver Nanoparticles Using Salvia officinalis Leaf Extract and its Catalytic Activity Towards Congo Red Dye Degradation. J. Mater. Res. Technol. 2020, 9, 10031–10044. [Google Scholar] [CrossRef]
- Umavathi, S.; Mahboob, S.; Govindarajan, M.; Al-Ghanim, K.A.; Ahmed, Z.; Virik, P.; Al-Mulhm, N.; Subash, M.; Gopinath, K.; Kavitha, C. Green Synthesis of ZnO Nanoparticles for Antimicrobial and Vegetative Growth Applications: A Novel Approach for Advancing Efficient High Quality Health Care to Human Wellbeing. Saudi J. Bio. Sci. 2021, 28, 1808–1815. [Google Scholar] [CrossRef] [PubMed]
- Naiel, B.; Fawzy, M.; Halmy, N.W.A.; Mahmoud, A.E.D. Green Synthesis of Zinc Oxide Nanoparticles Using Sea Lavender (Limonium pruinosum L. Chaz.) Extract: Characterization, Evaluation of Anti-skin Cancer, Antimicrobial and Antioxidant Potentials. Sci. Rep. 2022, 12, 20370. [Google Scholar] [CrossRef] [PubMed]
- Mohammed, Y.H.I.; Alghamdi, S.; Jabbar, B.; Marghani, D.; Beigh, S.; Abouzied, A.S.; Khalifa, N.E.; Khojali, W.M.A.; Huwaimel, B.; Alkhalifah, D.H.M.; et al. Green Synthesis of Zinc Oxide Nanoparticles Using Cymbopogon citratus Extract and its Antibacterial Activity. ACS Omega 2023, 8, 32027–32042. [Google Scholar] [CrossRef] [PubMed]
- MuthuKathija, M.; Badhusha, M.S.M.; Rama, V. Green Synthesis of Zinc Oxide Nanoparticles Using Pisonia alba Leaf Extract and its Antibacterial Activity. Appl. Surf. Sci. Adv. 2023, 15, 100400. [Google Scholar] [CrossRef]
- Bala, N.; Saha, S.; Chakraborty, M.; Maiti, M.; Das, S.; Basub, R.; Nandy, P. Green Synthesis of Zinc Oxide Nanoparticles Using Hibiscus subdariffa Leaf Extract: Effect of Temperature on Synthesis, Anti-bacterial Activity and Anti-diabetic Activity. RSC Adv. 2015, 5, 4993–5003. [Google Scholar] [CrossRef]
- Thema, F.T.; Manikandan, E.; Dhlamini, M.S.; Maaza, M. Green Synthesis of ZnO Nanoparticles Via Agathosma vetulina Natural Extract. Mater. Lett. 2015, 161, 124–127. [Google Scholar] [CrossRef]
- Soto-Robles, C.A.; Luque, P.A.; Gómez-Gutiérrez, C.M.; Nava, O.; Vilchis-Nestor, A.R.; Lugo-Medina, E.; Ranjithkumar, R.; Castro-Beltrán, A. Study on The Effect of the Concentration of Hibiscus sabdariffa Extract on the Green Synthesis of ZnO Nanoparticles. Results Phys. 2019, 15, 102807. [Google Scholar] [CrossRef]
- Stan, M.; Popa, A.; Toloman, D.; Silipas, T.-D.; Vodnar, D.C. Antibacterial and Antioxidant Activities of ZnO Nanoparticles Synthesized Using Extracts of Allium sativum, Rosmarinus officinalis and Ocimum basilicum. Acta Metall. Sin. (Engl. Lett.) 2016, 29, 228–236. [Google Scholar] [CrossRef]
- Mahendiran, D.; Subash, G.; Selvan, D.A.; Rehana, D.; Kumar, R.S.; Rahiman, A.K. Biosynthesis of Zinc Oxide Nanoparticles Using Plant Extracts of Aloe vera and Hibiscus sabdariffa: Phytochemical, Antibacterial, Antioxidant and Anti-proliferative Studies. BioNanoSci. 2017, 7, 530–545. [Google Scholar] [CrossRef]
- Demissie, M.G.; Sabir, F.K.; Edossa, G.D.; Gonfa, B.A. Synthesis of Zinc Oxide Nanoparticles Using Leaf Extract of Lippia adoensis (Koseret) and Evaluation of its Antibacterial Activity. J. Chem. 2020, 2020, 7459042. [Google Scholar] [CrossRef]
- Kamble, R.; Sathaye, S.; Shah, D.P. Evaluation of Antispasmodic Activity of Different Shodhit Guggul Using Different Shodhan Process. Indian J. Pharm. Sci. 2008, 70, 368–372. [Google Scholar]
- Revankar, A.G.; Bagewadi, Z.K.; Shaikh, I.A.; Mannasaheb, B.A.; Ghoneim, M.M.; Khan, A.A.; Asdaq, S.M.B. In-vitro and Computational Analysis of Urolithin-A for Anti-inflammatory Activity on Cyclooxygenase 2 (COX-2). Saudi J. Biol. Sci. 2023, 30, 103804. [Google Scholar] [CrossRef]
- Chatterjee, S.; Jaiganesh, R.; Rajeshkumar, S. Green Synthesis of Zinc Oxide Nanoparticles Using Chamomile and Green Tea Extracts and Evaluation of Their Anti-inflammatory and Antioxidant Activity: An in-vitro Study. Cureus 2023, 15, e46088. [Google Scholar] [CrossRef]
- Dua, T.K.; Giri, S.; Nandi, G.; Sahu, R.; Shaw, T.K.; Paul, P. Green Synthesis of Silver Nanoparticles Using Eupatorium adenophorum Leaf Extract: Characterizations, Antioxidant, Antibacterial and Photocatalytic Activities. Chem. Pap. 2023, 77, 2947–2956. [Google Scholar] [CrossRef] [PubMed]
- Barzinjy, A.A.; Azeez, H.H. Green Synthesis and Characterization of Zinc Oxide Nanoparticles using Eucalyptus globulus Labill. Leaf Extract and Zinc Nitrate Hexahydrate Salt. SN Appl. Sci. 2020, 2, 991. [Google Scholar] [CrossRef]
- Keshavarzi, Z.; Banadkoki, S.B.; Faizi, M.; Zolghadri, Y.; Shirazi, F.H. Comparison of Transmission FTIR and ATR Spectra for Discrimination between Beef and Chicken Meat and Quantification of Chicken in Beef Meat Mixture using ATR-FTIR Combined with Chemometrics. J. Food Sci. Technol. 2020, 57, 1430–1438. [Google Scholar] [CrossRef] [PubMed]
- Faisal, F.; Jan, H.; Shah, S.A.; Shah, S.; Khan, A.; Akbar, M.T.; Rizwan, M.; Jan, F.; Wajidullah; Akhtar, N.; et al. Green Synthesis of Zinc Oxide (ZnO) Nanoparticles Using Aqueous Fruit Extracts of Myristica fragrans: Their Characterizations and Biological and Environmental Applications. ACS Omega 2021, 6, 9709–9722. [Google Scholar] [CrossRef]
- Singh, D.K.; Pandey, D.K.; Yadav, R.R.; Singh, D. A Study of Nanosized Zinc Oxide and its Nanofluid. Pramana—J. Phys. 2012, 78, 759–766. [Google Scholar] [CrossRef]
- Zhou, X.-Q.; Hayat, Z.; Zhang, D.-D.; Li, M.-Y.; Hu, S.; Wu, Q.; Cao, Y.-F.; Yuan, Y. Zinc Oxide Nanoparticles: Synthesis, Characterization, Modification, and Applications in Food and Agriculture. Processes 2023, 11, 1193. [Google Scholar] [CrossRef]
- Dayakar, T.; Venkateswara, R.K.; Bikshalu, K.; Rajendar, V.; Park, S.-H. Novel Synthesis and Structural Analysis of Zinc Oxide Nanoparticles for the Non Enzymatic Glucose Biosensor. Mater. Sci. Eng. C 2017, 75, 1472–1479. [Google Scholar] [CrossRef]
- Priya, M.; Venkatesan, R.; Deepa, S.; Sana, S.S.; Arumugam, A.; Karami, A.M.; Vetcher, A.A.; Kim, S.-C. Green Synthesis, Characterization, Antibacterial, and Antifungal Activity of Copper Oxide Nanoparticles derived from Morinda citrifolia Leaf Extract. Sci. Rep. 2023, 13, 18838. [Google Scholar] [CrossRef]
- Venkatesan, R.; Rajeswari, N. ZnO/PBAT Nanocomposite Films: Investigation on the Mechanical and Biological Activity for Food Packaging. Polym. Adv. Technol. 2017, 28, 20–27. [Google Scholar] [CrossRef]
- Pandiyan, I.; Arumugham, M.; Srisakthi, D.; Shanumugam, R. Anti-inflammatory and Antioxidant Activity of Ocimum tenuiflorum- and Stevia rebaudiana-Mediated Silver Nanoparticles: An In Vitro Study. Cureus 2023, 15, e50109. [Google Scholar] [CrossRef] [PubMed]
- Stout, A.J.; Mirliani, A.B.; Rittenberg, M.L.; Shub, M.; White, E.C.; Yuen, J.S.K., Jr.; Kaplan, D.L. Simple and Effective Serum-Free Medium for Sustained Expansion of Bovine Satellite Cells for Cell Cultured Meat. Commun. Biol. 2022, 5, 466. [Google Scholar] [CrossRef] [PubMed]
- Mohamed, S.H.; Mohamed, W.S.; Shaheen, M.N.F.; Elmahdy, E.M.; Mabrouk, M.I. Cytotoxicity, Antibiotic Combination and Antiviral Activity of Papain Enzyme: In vitro study. Asian J. Res. Pharm. Sci. 2020, 10, 6–10. [Google Scholar] [CrossRef]
- Naseer, M.; Aslam, U.; Khalid, B.; Chen, B. Green route to synthesize Zinc Oxide Nanoparticles using Leaf Extracts of Cassia fistula and Melia azadarach and Their Antibacterial Potential. Sci. Rep. 2020, 10, 9055. [Google Scholar] [CrossRef]
- Banoee, M.; Seif, S.; Nazari, Z.E.; Jafari-Fesharaki, P.; Shahverdi, H.R.; Moballegh, A.; Moghaddam, K.M.; Shahverdi, A.R. ZnO Nanoparticles Enhanced Antibacterial Activity of Ciprofloxacin against Staphylococcus aureus and Escherichia coli. J. Biomed. Mater. Res.—B 2010, 93B, 557–561. [Google Scholar] [CrossRef] [PubMed]

| S. No | Design of Treatment | Dose (mg/kg) | Temperature (°C) | Temperature (°C) | Decrease in Temperature after 2 h (°C) |
|---|---|---|---|---|---|
| 1. | Saline | 10 mL/kg | 36.9 | 38.9 | 38.7 |
| 2. | Paracetamol (standard) | 100 mL/kg | 36.8 | 39.0 | 38.2 |
| 3. | Sample (test drug) | 100 mL/mg | 37.3 | 39.3 | 37.9 |
Disclaimer/Publisher’s Note: The statements, opinions and data contained in all publications are solely those of the individual author(s) and contributor(s) and not of MDPI and/or the editor(s). MDPI and/or the editor(s) disclaim responsibility for any injury to people or property resulting from any ideas, methods, instructions or products referred to in the content. |
© 2024 by the authors. Licensee MDPI, Basel, Switzerland. This article is an open access article distributed under the terms and conditions of the Creative Commons Attribution (CC BY) license (https://creativecommons.org/licenses/by/4.0/).
Share and Cite
Sugitha, S.K.J.; Venkatesan, R.; Latha, R.G.; Vetcher, A.A.; Al-Asbahi, B.A.; Kim, S.-C. A Study on the Antibacterial, Antispasmodic, Antipyretic, and Anti-Inflammatory Activity of ZnO Nanoparticles Using Leaf Extract from Jasminum sambac (L. Aiton). Molecules 2024, 29, 1464. https://doi.org/10.3390/molecules29071464
Sugitha SKJ, Venkatesan R, Latha RG, Vetcher AA, Al-Asbahi BA, Kim S-C. A Study on the Antibacterial, Antispasmodic, Antipyretic, and Anti-Inflammatory Activity of ZnO Nanoparticles Using Leaf Extract from Jasminum sambac (L. Aiton). Molecules. 2024; 29(7):1464. https://doi.org/10.3390/molecules29071464
Chicago/Turabian StyleSugitha, S. K. Johnsy, Raja Venkatesan, R. Gladis Latha, Alexandre A. Vetcher, Bandar Ali Al-Asbahi, and Seong-Cheol Kim. 2024. "A Study on the Antibacterial, Antispasmodic, Antipyretic, and Anti-Inflammatory Activity of ZnO Nanoparticles Using Leaf Extract from Jasminum sambac (L. Aiton)" Molecules 29, no. 7: 1464. https://doi.org/10.3390/molecules29071464
APA StyleSugitha, S. K. J., Venkatesan, R., Latha, R. G., Vetcher, A. A., Al-Asbahi, B. A., & Kim, S.-C. (2024). A Study on the Antibacterial, Antispasmodic, Antipyretic, and Anti-Inflammatory Activity of ZnO Nanoparticles Using Leaf Extract from Jasminum sambac (L. Aiton). Molecules, 29(7), 1464. https://doi.org/10.3390/molecules29071464

